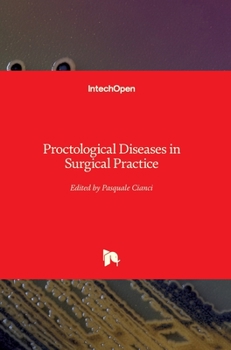
Hardcover Proctological Diseases in Surgical Practice Book

Proctological Diseases in Surgical Practice
No Synopsis Available.
Format:Hardcover
Language:English
ISBN:1789236347
ISBN13:9781789236347
Release Date:August 2018
Publisher:Intechopen
Length:170 Pages
Weight:1.04 lbs.
Dimensions:0.4" x 6.7" x 9.6"
Customer Reviews
0 rating